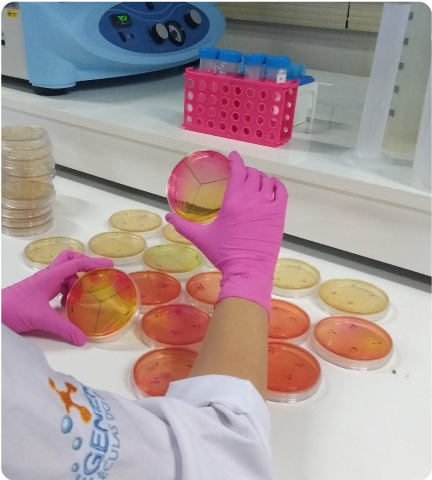
bioensaio ensaios biológicos

Unimos microbiologia, bioprocessos e química analítica para soluções sustentáveis e inovadoras.
Serviços e Consultoria especializada
Nossas soluções para uma inovação sustentável
Análises químicas de produtos naturais
Mapeamos e isolamos compostos bioativos por técnicas de cromatografia, gerando conhecimento para aplicações em diversos segmentos.
Estudos biotecnológicos avançados
Estudos microbiológicos e genéticos completos para a caracterização de linhagens, mecanismos de ação e desenvolvimento de compostos bioativos.
Da descoberta até a otimização e escalonamento de bioprocessos
Desenvolvemos e otimizamos bioprocessos eficientes para transformar recursos biotecnológicos em soluções sustentáveis, escaláveis e altamente inovadoras.
Pesquisa que conecta ciência, mar e futuro
Cada descoberta nasce de uma pergunta: como transformar a riqueza dos oceanos em soluções sustentáveis? Com rigor científico e responsabilidade ambiental, desenvolvemos serviços que unem inovação e respeito à biodiversidade marinha.
Diferenciais
Por que inovar com a Regenera?
Amazônia Azul
Biodiversidade ímpar e rica em recursos naturais capazes de originar novos compostos biotecnológicos.
Potencial biotecnológico
Pesquisa e desenvolvimento de bioprodutos e bioprocessos avançados, com foco no benefício humano, animal e ambiental.
Moléculas mais potentes
Identificação de moléculas bioativas e microrganismos com atividades biológicas diferenciadas e inovadoras.
Pioneirismo
Primeira empresa no mundo a disponibilizar um banco de microrganismos marinhos oriundos da Amazônia Azul com foco no desenvolvimento tecnológico e inovação.
Vantagens geográficas
Localização privilegiada, possibilitando acesso a recursos únicos para o desenvolvimento de soluções inovadoras para o seu negócio.
Sustentabilidade
Produtos e processos que contribuem para a preservação e recuperação dos oceanos, tendo como premissa o uso sustentável da biodiversidade marinha brasileira.
Rede de parceiros
Conexões para o sucesso
Empresa de base tecnológica que tem como missão disponibilizar a biodiversidade química brasileira de origem marinha para as necessidades de inovação da indústria.
Soluções
Pesquisa, Desenvolvimento & Inovação
Serviços Tecnológicos
Consultoria Científica
Banco Regenera
Contato
Entre em contato através do telefone e e-mail abaixo.